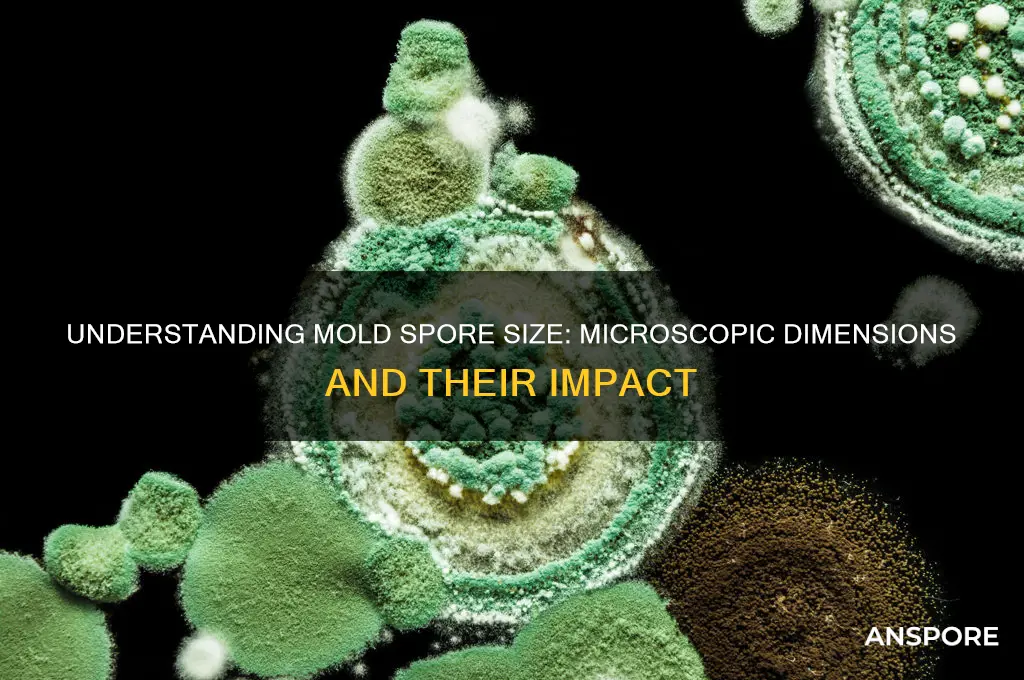
how large is a mold spore

Mold spores are microscopic in size, typically ranging from 2 to 100 micrometers (μm) in diameter, making them invisible to the naked eye. For context, a human hair is about 75 to 100 μm wide, so mold spores are significantly smaller. Their tiny size allows them to remain airborne for extended periods, easily spreading through indoor and outdoor environments. Despite their minuscule dimensions, mold spores are resilient and can survive harsh conditions, making them a persistent concern in areas with moisture issues. Understanding their size is crucial for effective detection, prevention, and remediation strategies.
| Characteristics | Values |
|---|---|
| Size Range | Typically 2 to 20 micrometers (μm) in diameter |
| Average Size | Around 3 to 4 micrometers (μm) |
| Comparison to Human Hair | Approximately 50 to 100 times smaller than the width of a human hair (which is about 50 to 100 μm) |
| Visibility | Generally not visible to the naked eye; requires a microscope for detection |
| Shape | Varies by species; common shapes include spherical, oval, or cylindrical |
| Weight | Extremely lightweight, with some spores weighing as little as 1 nanogram (ng) |
| Airborne Capability | Easily become airborne due to their small size and lightweight nature |
| Survival in Environment | Can remain viable for long periods, ranging from weeks to years, depending on conditions |
| Species Variation | Size can differ significantly between mold species (e.g., Aspergillus spores are smaller than Stachybotrys spores) |
| Detection Method | Measured using tools like microscopes, spore traps, or air sampling devices |
Explore related products
$13.48 $14.13
What You'll Learn
- Spore Size Range: Mold spores typically measure 2-20 microns in diameter
- Comparison to Dust: Mold spores are smaller than dust particles, often invisible to the eye
- Species Variation: Spore size varies by mold species, influencing dispersal and detection methods
- Airborne Capability: Small size allows spores to remain airborne for extended periods
- Detection Limits: Specialized equipment is needed to detect spores due to their microscopic size

Spore Size Range: Mold spores typically measure 2-20 microns in diameter
Mold spores, the microscopic seeds of fungi, are remarkably small yet play a significant role in both natural ecosystems and indoor environments. Their size, typically ranging from 2 to 20 microns in diameter, is a critical factor in their ability to disperse and survive. To put this into perspective, a human hair averages about 75 microns in width, making mold spores invisible to the naked eye. This minuscule size allows them to float effortlessly in the air, travel long distances, and infiltrate even the smallest cracks and crevices. Understanding this size range is essential for anyone dealing with mold prevention or remediation, as it highlights the challenge of controlling their spread.
Consider the practical implications of this size range in everyday scenarios. For instance, standard HVAC filters with a MERV rating below 8 are ineffective at capturing particles smaller than 3 microns, meaning many mold spores can pass through unimpeded. To combat this, homeowners and building managers should opt for high-efficiency particulate air (HEPA) filters or those with a MERV rating of 13 or higher, which can trap particles as small as 0.3 microns. Additionally, because mold spores are so lightweight, they remain suspended in the air longer than larger particles, increasing the likelihood of inhalation. This underscores the importance of proper ventilation and air purification systems, especially in damp or mold-prone areas.
From a comparative standpoint, the size of mold spores places them in a unique category among airborne particles. Pollen grains, for example, range from 10 to 100 microns, making them significantly larger and easier to filter. Dust mites, another common allergen, are around 100 to 300 microns in size. Mold spores’ smaller size not only makes them harder to detect but also more likely to penetrate deep into the respiratory system, potentially causing allergic reactions or exacerbating asthma. This distinction highlights why mold spores require specialized detection methods, such as air sampling or spore traps, to accurately assess their presence in indoor environments.
For those tasked with mold remediation, the spore size range dictates specific strategies. During cleanup, disturbing mold colonies can release millions of spores into the air, creating a hazardous situation. Professionals use containment barriers and negative air pressure systems to prevent spores from spreading to unaffected areas. Personal protective equipment (PPE), including N95 respirators, is essential because these masks are designed to filter out particles as small as 0.3 microns. DIY enthusiasts should exercise caution: while small-scale mold removal is manageable, larger infestations (over 10 square feet) require professional intervention to avoid widespread spore dispersal.
Finally, the size of mold spores offers insights into their resilience and adaptability. Their compact structure allows them to withstand harsh conditions, such as extreme temperatures and low humidity, ensuring their survival until they land in a suitable environment for growth. This tenacity is why mold prevention focuses on controlling moisture—the one factor spores cannot thrive without. Regular inspections of areas prone to dampness, such as basements, bathrooms, and attics, coupled with prompt repairs of leaks or water damage, are the most effective measures. By understanding the spore size range, individuals can implement targeted strategies to minimize mold risks and maintain healthier indoor spaces.
Owning Psilocybin Spores in California: Legalities and What You Need to Know
You may want to see also

Comparison to Dust: Mold spores are smaller than dust particles, often invisible to the eye
Mold spores, typically measuring between 3 to 40 microns in size, are significantly smaller than the average dust particle, which ranges from 2.5 to 100 microns. This size disparity is crucial because it determines how these particles interact with our environment and bodies. While dust can often be seen settling on surfaces or floating in a sunbeam, mold spores remain largely invisible, making them harder to detect without specialized tools. This invisibility underscores the importance of understanding their presence, especially in environments prone to moisture and humidity, where mold thrives.
Consider the practical implications of this size difference. Dust particles, being larger, are more likely to settle on surfaces or be trapped by air filters. Mold spores, however, can remain suspended in the air for extended periods, increasing the likelihood of inhalation. For individuals with allergies or respiratory conditions, this distinction is critical. While dust may cause temporary discomfort, mold spores can lead to more severe health issues, such as asthma exacerbations or fungal infections. Knowing this, it’s essential to use HEPA filters, which can capture particles as small as 0.3 microns, to mitigate mold spore exposure in indoor spaces.
To illustrate, imagine a scenario where a homeowner notices a musty odor but sees no visible mold. The absence of visible mold doesn’t mean it’s not present; the spores could be airborne, too small to see. In such cases, testing the air for mold spores becomes necessary. DIY mold test kits, which collect air samples and send them to labs for analysis, can detect spore concentrations as low as 10 spores per cubic meter. For context, the EPA recommends addressing mold issues when spore counts exceed 1,000 spores per cubic meter, though sensitive individuals may react at lower levels.
From a preventive standpoint, controlling moisture is key to minimizing mold spore proliferation. Dust, while unsightly, doesn’t require the same level of environmental management. Mold, however, needs moisture to grow, and spores can germinate within 24 to 48 hours in damp conditions. Practical steps include fixing leaks promptly, maintaining indoor humidity below 60%, and ensuring proper ventilation in areas like bathrooms and kitchens. Regularly cleaning surfaces with mold-inhibiting solutions, such as a 1:8 bleach-to-water mixture, can also help prevent spore colonization.
In summary, while dust and mold spores share the air we breathe, their size difference dictates distinct behaviors and health risks. Dust is larger, more visible, and easier to manage, whereas mold spores are microscopic, persistent, and potentially harmful. By understanding this comparison, individuals can take targeted actions—from using HEPA filters to controlling humidity—to protect their health and maintain a mold-free environment. Awareness of these differences transforms invisible threats into manageable challenges.
Spore and Cone Bearing Plants: Unveiling Unique Reproduction Strategies
You may want to see also

Species Variation: Spore size varies by mold species, influencing dispersal and detection methods
Mold spores, the reproductive units of fungi, exhibit a remarkable diversity in size, a characteristic that is intrinsically linked to the species from which they originate. This variation is not arbitrary; it plays a pivotal role in how these spores disperse through the environment and how they are detected, both in natural settings and in controlled laboratory conditions. For instance, spores from the *Aspergillus* genus typically range from 2 to 5 micrometers in diameter, while those of *Cladosporium* can be slightly larger, around 3 to 6 micrometers. These size differences are not merely biological curiosities—they directly influence the spores' ability to travel on air currents, with smaller spores generally achieving greater dispersal distances due to their lower settling velocity.
Understanding spore size is critical for effective mold detection and remediation. Larger spores, such as those of *Stachybotrys* (often referred to as black mold), are more easily captured by standard air sampling methods but may not travel as far indoors, limiting their spread to localized areas. Conversely, smaller spores, like those of *Penicillium*, can remain airborne longer and infiltrate HVAC systems, making them more challenging to detect without specialized equipment. For professionals in mold assessment, this means tailoring sampling strategies to the suspected species—using spore traps for larger spores and air pumps with finer filters for smaller ones. Homeowners can benefit from this knowledge too: if *Cladosporium* is suspected, for example, regular cleaning of air vents and filters can reduce spore accumulation.
The ecological implications of spore size variation are equally fascinating. Smaller spores, such as those of *Alternaria*, are more likely to be carried over long distances by wind, facilitating their colonization of new habitats. This adaptability contributes to their prevalence in outdoor environments and their role as common allergens. In contrast, larger spores, like those of *Basidiomycetes*, often rely on shorter-range dispersal mechanisms, such as water splashes or insect vectors, which limits their spread but ensures targeted deposition in suitable environments. This species-specific dispersal strategy underscores the evolutionary significance of spore size, shaping fungal ecosystems in ways that are only beginning to be fully understood.
Practical applications of this knowledge extend into public health and industrial settings. For example, in hospitals, where mold contamination can pose serious risks to immunocompromised patients, understanding the spore size of common indoor molds like *Aspergillus fumigatus* (3-5 micrometers) helps in designing filtration systems that effectively capture these particles. Similarly, in food production facilities, where molds like *Penicillium* can spoil products, monitoring for smaller spores requires more sensitive detection methods, such as PCR-based assays, to ensure early intervention. By recognizing the relationship between spore size, species, and behavior, professionals can implement more targeted and effective control measures.
In conclusion, the size of mold spores is a critical factor that varies significantly across species, influencing both their dispersal patterns and the methods used to detect them. This variation has profound implications for environmental science, public health, and industrial practices. Whether you're a homeowner concerned about indoor air quality, a scientist studying fungal ecology, or a professional in mold remediation, understanding these species-specific differences can lead to more informed decisions and effective solutions. By focusing on spore size as a key characteristic, we can better navigate the complex world of mold and its impact on our lives.
Understanding Sori: Mitosis or Meiosis in Spore Production Explained
You may want to see also
Explore related products

Airborne Capability: Small size allows spores to remain airborne for extended periods
Mold spores, typically measuring between 2 to 20 micrometers in diameter, are remarkably small—smaller than a grain of sand and invisible to the naked eye. This minuscule size is not just a biological curiosity; it’s a key factor in their airborne capability. At this scale, spores are light enough to be carried by even the gentlest air currents, allowing them to remain suspended in the atmosphere for hours or even days. This extended airborne lifespan significantly increases their dispersal range, enabling them to travel across rooms, buildings, or even entire cities. Understanding this phenomenon is crucial for anyone dealing with mold prevention or remediation, as it highlights why spores are so pervasive and difficult to contain.
Consider the practical implications of this airborne capability in indoor environments. A single disturbed mold colony can release millions of spores into the air, where they can circulate through HVAC systems, settle on surfaces, or be inhaled by occupants. For example, in a poorly ventilated basement, spores released from damp drywall can remain airborne long enough to spread to upper floors, colonizing new areas before they’re even detected. This is why mold infestations often seem to appear suddenly—the spores have been silently traveling and accumulating over time. To mitigate this, experts recommend using HEPA filters and maintaining proper ventilation to reduce spore concentration in the air.
From a health perspective, the small size and airborne persistence of mold spores pose unique risks, particularly for individuals with allergies, asthma, or compromised immune systems. Studies show that prolonged exposure to airborne spores can lead to respiratory issues, with concentrations as low as 1,000 spores per cubic meter triggering symptoms in sensitive individuals. Children and the elderly are especially vulnerable, as their immune systems are less equipped to handle prolonged exposure. Practical steps to minimize risk include regularly inspecting areas prone to moisture (e.g., bathrooms, kitchens) and using dehumidifiers to keep humidity levels below 50%, as spores thrive in damp conditions.
Comparatively, the airborne behavior of mold spores contrasts sharply with larger particles like dust or pollen. While pollen grains (typically 10-100 micrometers) settle quickly due to their size, mold spores’ smaller mass allows them to evade gravity’s pull, remaining aloft until they encounter a suitable surface to colonize. This distinction underscores why mold is a more insidious problem in indoor spaces—it’s not just about what you see, but what you can’t see lingering in the air. For homeowners, this means that surface cleaning alone is insufficient; addressing airborne spores through air purification and moisture control is equally critical.
In conclusion, the small size of mold spores is not merely a biological trait—it’s a strategic advantage that enables their widespread dispersal and persistence. By understanding this airborne capability, individuals can take targeted steps to prevent mold growth and protect their health. From investing in air quality monitors to adopting proactive moisture management practices, the key is to disrupt the spores’ ability to remain airborne and find new habitats. In the battle against mold, knowledge of its microscopic size is a powerful weapon.
Does Spore Work on Windows 7 64-Bit? Compatibility Guide
You may want to see also

Detection Limits: Specialized equipment is needed to detect spores due to their microscopic size
Mold spores, typically ranging from 2 to 100 micrometers in size, are invisible to the naked eye. For context, a human hair averages about 75 micrometers in diameter, meaning many spores are smaller than a single strand. This microscopic scale necessitates specialized equipment for accurate detection, as reliance on visual inspection alone is insufficient. Without such tools, mold infestations can go unnoticed until they become severe, posing health risks and structural damage.
Detecting mold spores requires precision instruments like optical microscopes, scanning electron microscopes (SEMs), or air sampling devices. Optical microscopes, with magnification capabilities up to 1000x, are commonly used for initial identification but may struggle with smaller spores. SEMs, offering up to 500,000x magnification, provide detailed imaging but are costly and time-consuming. Air sampling devices, such as spore traps or impaction samplers, collect airborne spores for laboratory analysis, offering quantitative data on spore concentration. Each tool serves a specific purpose, but none are interchangeable, highlighting the complexity of detection.
For homeowners or professionals, selecting the right equipment depends on the detection goal. Portable air quality monitors with particle counters can provide real-time data on spore levels, typically detecting particles as small as 0.3 micrometers. However, these devices do not identify mold species, only indicating the presence of particles. For species identification, tape lifts or swab samples paired with laboratory analysis are necessary. Understanding these limitations ensures appropriate tool selection and accurate results.
Health agencies, such as the EPA, recommend mold testing when visible growth exceeds 10 square feet or after water damage. Specialized equipment is critical in these scenarios, as spores can remain suspended in the air long after cleanup, posing ongoing health risks. For instance, *Stachybotrys chartarum* (black mold) spores, averaging 6-10 micrometers, are linked to respiratory issues and require precise detection methods. Without specialized tools, such hazards may persist undetected, underscoring the importance of professional assessment in high-risk situations.
In summary, the microscopic size of mold spores demands specialized equipment for detection, from high-magnification microscopes to air sampling devices. Each tool has unique capabilities and limitations, requiring careful selection based on the detection goal. Whether for home inspection or professional assessment, understanding these tools ensures accurate identification and mitigation of mold-related risks, safeguarding both health and property.
Turning Foes into Friends: Befriending Hostile Tribes in Spore
You may want to see also
Frequently asked questions
A typical mold spore ranges in size from 2 to 100 micrometers (μm) in diameter, though most fall between 3 and 40 μm.
No, individual mold spores are too small to be seen without magnification. They become visible only when they accumulate in large clusters or colonies.
Mold spores are generally smaller than pollen grains, which typically range from 10 to 100 μm in diameter.
No, the size of mold spores varies depending on the species of mold. For example, *Aspergillus* spores are smaller (2-3 μm), while *Stachybotrys* spores are larger (10-20 μm).
Yes, high-efficiency particulate air (HEPA) filters can effectively capture mold spores, as their size (typically 3-40 μm) is well within the range these filters are designed to trap.































